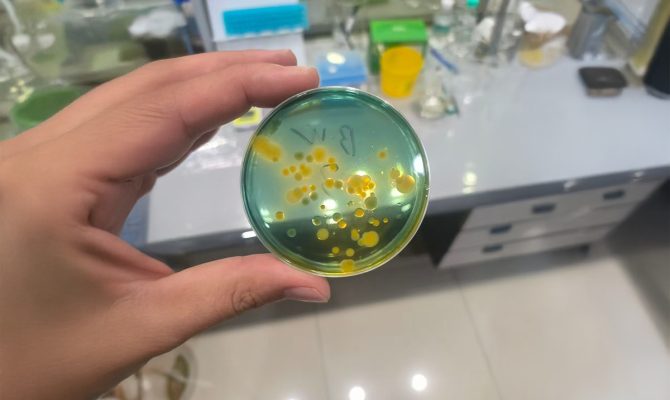

We supply ornamental fish to retailers and business partners nationwide, backed by high quality, reliability, and dependable logistics for your business needs.
Your Ultimate Aquatic & Pet Powerhouse
About Us
Qian Hu Aquarium And Pets (M) Sdn Bhd has earned its reputation as a reliable brand within the aquatic and pet industries, offering a wide range of products, distribution, and services, supported by years of experience in the industry.
We're here to help!
Talk to Us: 03 8724 9288
Explore Our Services
Complete Aquatic & Pet Solutions
We provide a complete line of aquatic and pet products for dealers and pet shops with consistent quality, excellent performance, and strong market appeal.
We provide aquarium and pond installations, maintenance, and system support, ensuring healthy system operation and consistent performance for all facilities.
We offer aquaculture testing, disease diagnostics and technical assistance without compromising result accuracy and management of aquatic health.
- Import & Export
- Wholesale Distribution
- Equipment Upkeep
- Fish Care Monitoring
- Water Quality Management
- PCR Testing
- Fish Disease Testing
- Aquaculture Lab Testing
- Import & Export
- Wholesale Distribution
- Equipment Upkeep
- Fire Care Monitoring
- Water Quality Management
- PCR Testing
- Fish Disease Testing
- Aquaculture Lab Testing
Flowerhorn fish
Hybrid ornamental aquarium fish known for its vivid colors and unique, protruding forehead a nuchal hump or kok hybrid species

Dragon cichlid
Is a large, aggressive freshwater fish admired for its vibrant color, bold personality, and distinctive hump like the Red Devil Cichlid

Crown pearl
Is a variety of Flowerhorn cichlid pearl base in aquatics, jewelry, or botany. Since your previous queries are about ornamental fish.

Thunder kok
It’s one of the most prized varieties among Flowerhorn enthusiasts, especially in competitive shows and luxury fish markets.

Feedbacks From Our Customers
Consistent 5-Star Experiences
Posted on Hing Derc Posted on Huai Shen 服务周到 态度好
Owner's reply
非常感谢您的 5 星好评!很高兴您对我们的服务和态度感到满意。我们会继续努力,为您提供更好的体验。期待您再次光临!Posted on PB11GILL ARABIAN TRUCKER We delivered goods here
Owner's reply
Thank you for the 5-star review! We appreciate your delivery and support. It was great having you here, and we look forward to future dealings together.Posted on BAT gGat Pink Very cooperative staffs, very familiar and pets heaven
Owner's reply
Thank you so much for your 5-star review with us and the community.








Stay Updated
Updates, Tips, and What's New at Qian Hu
Malaysia's top provider
for
aquatic & pet solutions
Our full ecosystem offering will help you at any level.
Call us anytime